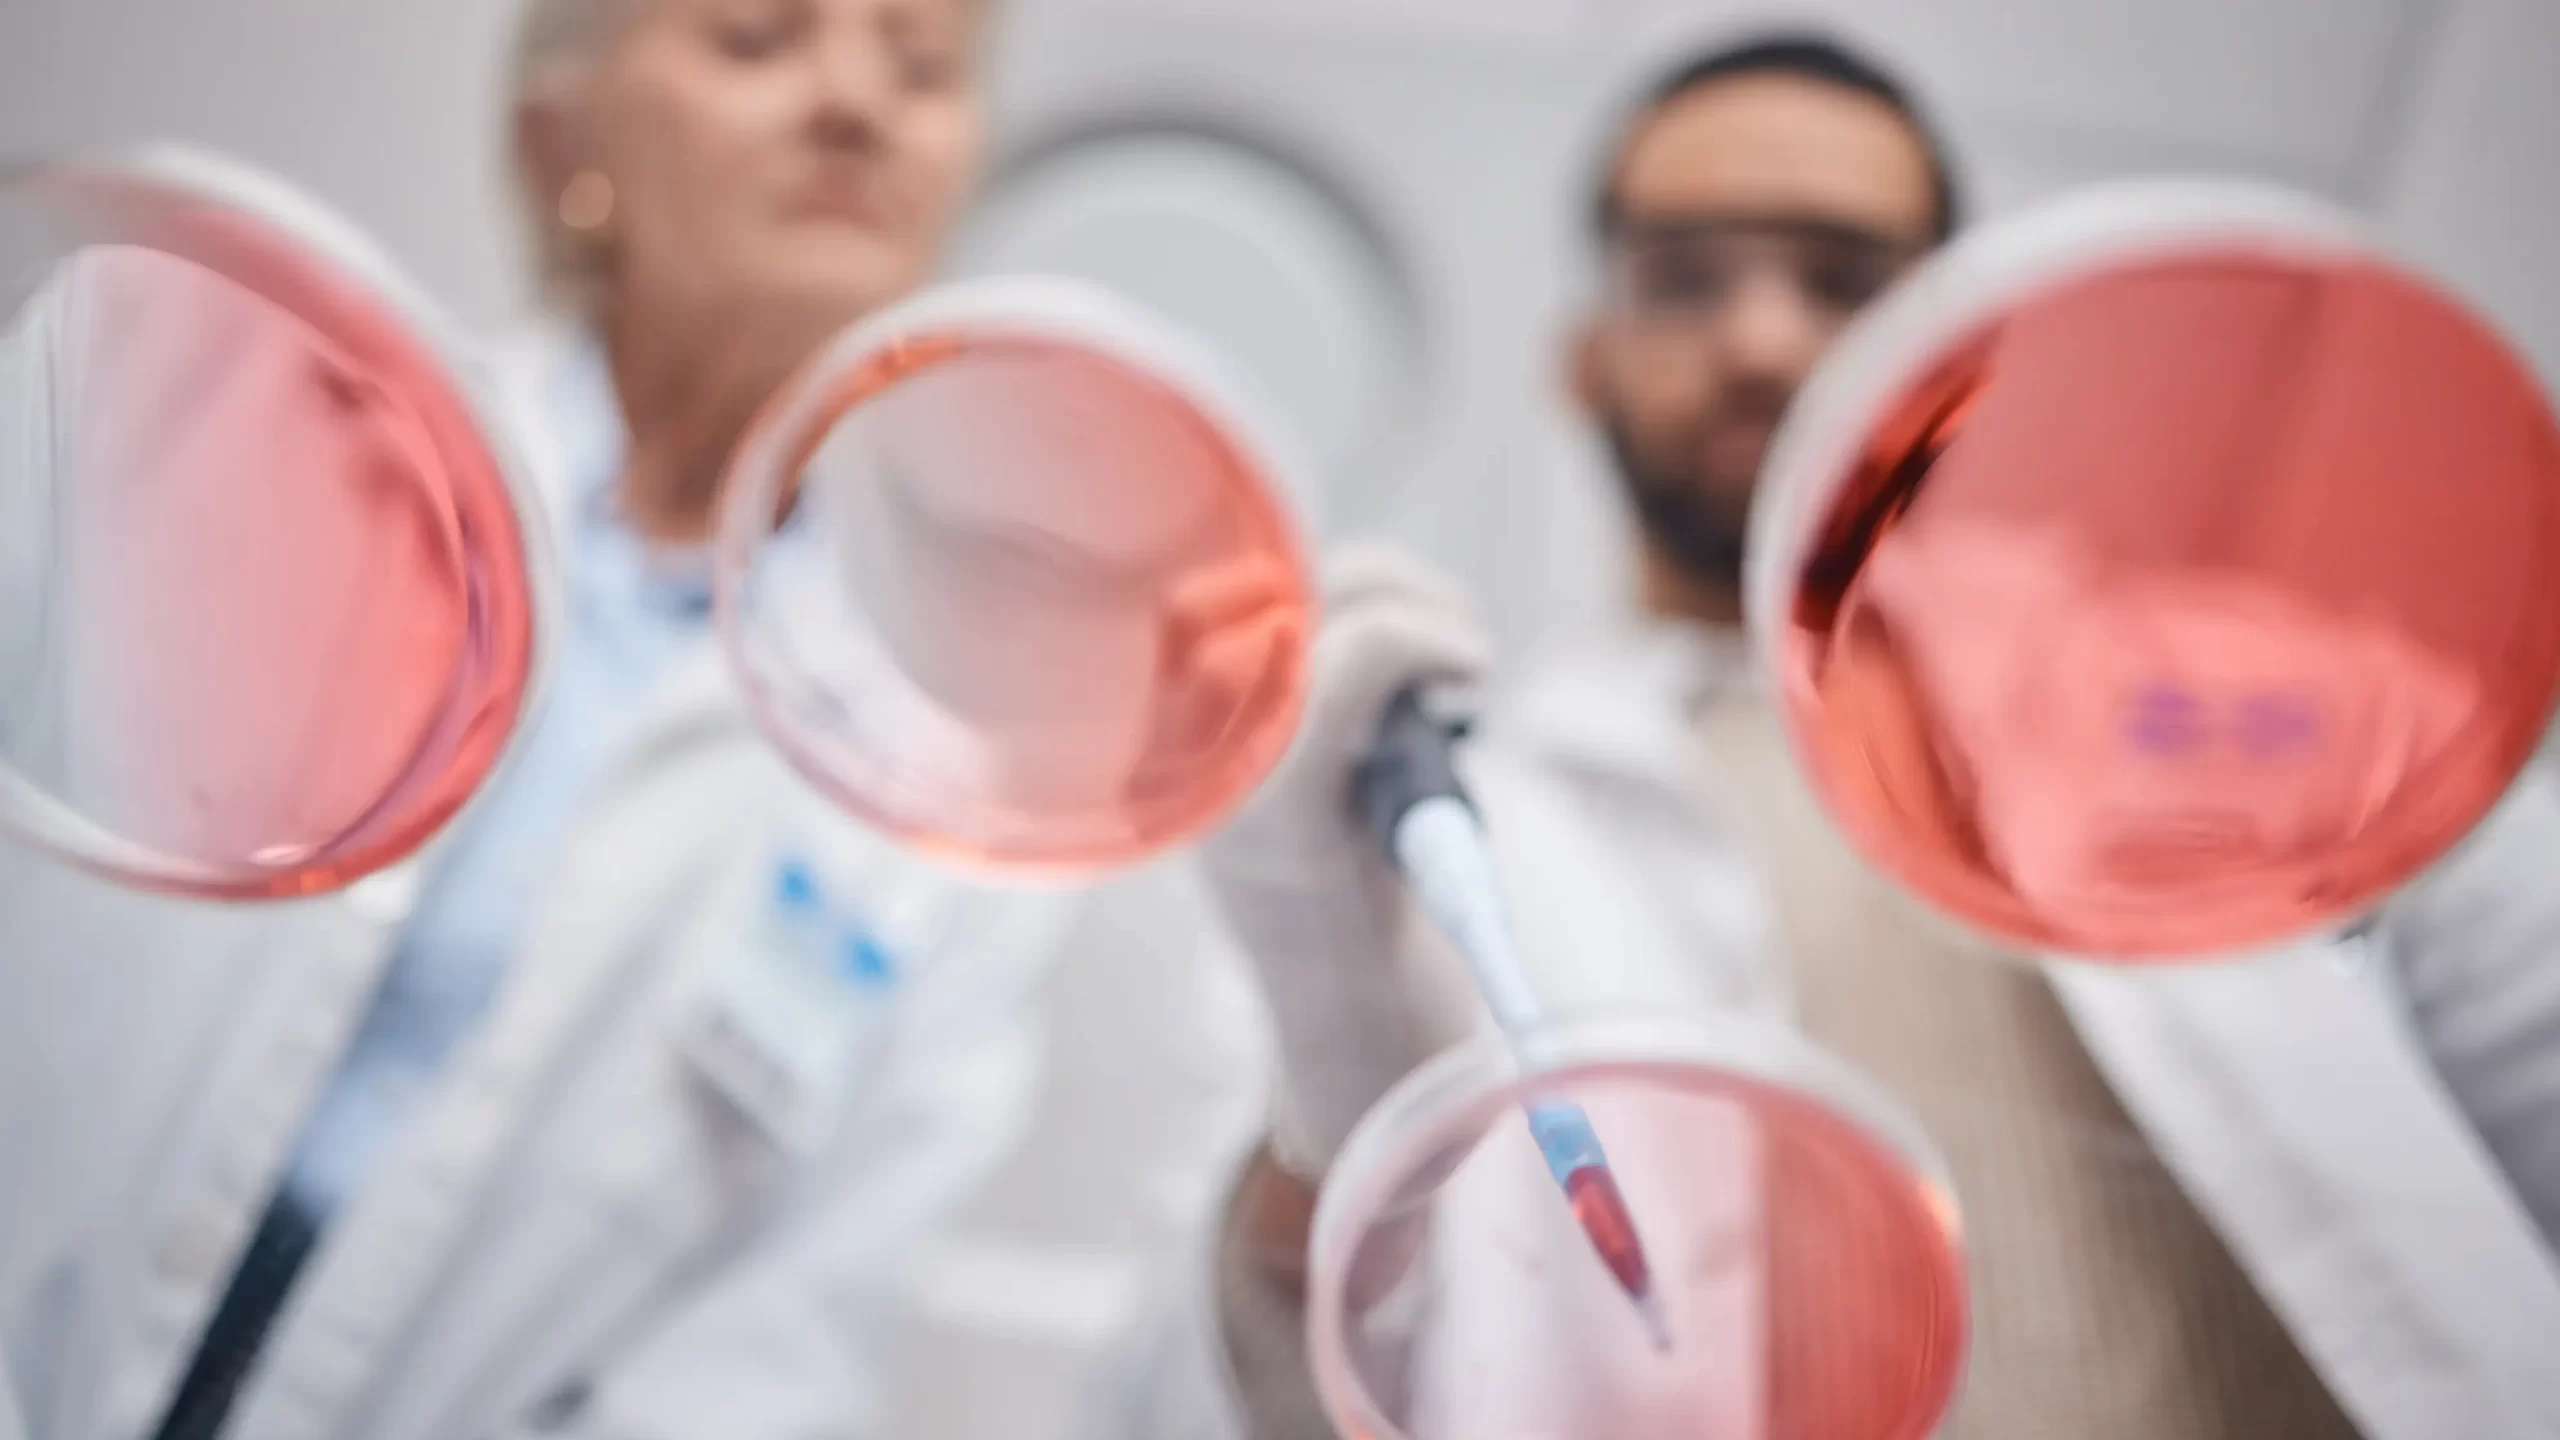
kok-hucre-nedir-ve-nasil-calisir

Kök Hücre
Kök hücre, vücudun farklı doku ve organlarını oluşturma potansiyeline sahip özel hücrelerdir. Bu hücreler kendilerini yenileyebilmektedir. Farklı hücre tiplerine dönüşebilme yeteneği taşımaktadır. Kök hücreler, tedavi amacıyla kullanılmaktadır. Böylece hasar görmüş dokuların veya organların onarılmasına yardımcı olabilmektedir. Günümüzde kanser, Parkinson, diyabet gibi birçok hastalığın tedavisinde kök hücre araştırmaları önemli bir rol oynamaktadır. Özellikle embriyonik kök hücreler ve yetişkin kök hücreler bu alanda en çok incelenen iki türdür. Kök hücre araştırmaları, tıp dünyasında çığır açıcı gelişmelerin kapısını aralamaktadır.

İçindekiler
- Kök Hücre Nedir ve Nasıl Çalışır?
- Kök Hücrelerin Elde Edilme Yöntemleri
- Kök Hücre Tedavisinin Kullanıldığı Hastalıklar
- Kök Hücrenin Cilt Sağlığına Faydaları
- Ortopedi ve Travmatolojide Kök Hücre: Cerrahiye Alternatif Yenilikçi Tedavi
- Kök Hücre Tedavisinde Kullanılan Yöntemler ve Uygulama Alanları
- Sıkça Sorulan Sorular ve Cevapları
- Op. Dr. Özgür Oktay Nar’dan Kök Hücre Tedavisi Hakkında Bilgilendirme
Kök Hücre Nedir ve Nasıl Çalışır?
Kök hücreler, vücuttaki diğer hücre tiplerine dönüşme yeteneğine sahip temel hücrelerdir. Bu hücreler, kendilerini sınırsız kez yenileyebilme kapasitesine sahip olmaktadır.İhtiyaç duyulduğunda kas, sinir, kan gibi özel hücrelere dönüşebilmektedir. Kök hücreler, vücudun gelişimi sırasında önemli bir rol oynamaktadır.Doku hasarlarını onarmak veya kaybolan hücreleri yenilemek için de kullanılabilmektedir. Bilim insanları, kök hücrelerin bu benzersiz özelliklerinden yararlanmaktadırlar. Bu şekilde pek çok hastalığın tedavisinde yeni yöntemler geliştirilmeye çalışılmaktadır.
Kök Hücrelerin Elde Edilme Yöntemleri
Kök hücreler, çeşitli kaynaklardan elde edilmektedir. En yaygın kök hücre kaynakları arasında embriyonik kök hücreler, yetişkin kök hücreleri ve göbek kordonu kanından elde edilen kök hücreler bulunmaktadır. Embriyonik kök hücreler, döllenmiş bir yumurtanın ilk aşamalarındaki embriyolardan alınmaktadır.Böylece birçok farklı hücre tipine dönüşebilme potansiyeline sahip olurlar. Yetişkin kök hücreleri ise kemik iliği, yağ dokusu veya kan gibi dokularda bulunmaktadır. Bu şekilde spesifik doku tiplerine dönüşebilmektedirler. Göbek kordonundan elde edilen kök hücreler ise doğum sırasında toplanabilmektedir. Bu, özellikle kan hastalıkları için umut vadeden bir kaynak olmaktadır. Bu farklı yöntemler, kök hücrelerin çeşitli tedavi ve araştırma alanlarında kullanılmasını mümkün kılmaktadır.

Kök Hücre Tedavisinin Kullanıldığı Hastalıklar
Kök hücre tedavisi, birçok hastalığın tedavisinde umut verici sonuçlar sunmaktadır. Özellikle kan hastalıkları, kanser türleri ve bağışıklık sistemi bozukluklarında yaygın olarak kullanılmaktadır. Lösemi ve lenfoma gibi kanser türlerinde kemik iliğinden alınan kök hücreler, sağlıklı kan hücrelerinin yeniden üretimini sağlamaktadır. Ayrıca Parkinson, Alzheimer, omurilik yaralanmaları ve multipl skleroz (MS) gibi nörolojik hastalıklarda kök hücre tedavisi üzerine araştırmalar devam etmektedir. Tip 1 diyabet, kalp hastalıkları ve bazı genetik bozuklukların tedavisinde de kök hücre terapileri potansiyel çözüm sunmaktadır. Bu tedavi yöntemi, hasarlı dokuların onarılması ve yeni sağlıklı hücrelerin üretilmesi üzerine odaklanmaktadır.

Kök Hücrenin Cilt Sağlığına Faydaları
Kök hücreler, cilt sağlığında yenileyici ve onarıcı özellikleriyle dikkat çekmektedir. Cilt hücrelerinin yenilenmesine yardımcı olmaktadır. Bu sayede kırışıklıkların, lekelerin ve yaşlanma belirtilerinin azalmasına katkıda bulunabilmektedir. Özellikle kozmetik ve dermatoloji alanında kullanılan kök hücre tedavileri, cildin elastikiyetini artırarak daha genç ve canlı bir görünüm sağlamayı amaçlamaktadır. Ayrıca yaraların iyileşmesini hızlandırmaktadır.Ciltteki hücre hasarlarını onarma potansiyeline sahip olmaktadır. Kök hücre bazlı tedaviler, ciltteki kolajen üretimini artırarak cildin daha pürüzsüz ve sağlıklı görünmesini desteklemektedir.

Ortopedi ve Travmatolojide Kök Hücre: Cerrahiye Alternatif Yenilikçi Tedavi
Ortopedi ve travmatoloji alanında kök hücreler, hasar görmüş kemik, kıkırdak, kas ve tendon dokularının onarılmasında büyük önem taşımaktadır. Özellikle eklem rahatsızlıkları, kireçlenme (osteoartrit), menisküs yırtıkları ve spor yaralanmalarında kök hücre tedavisi, doku yenilenmesini destekleyerek iyileşme sürecini hızlandırmaktadır. Kemik iliğinden veya yağ dokusundan elde edilen kök hücreler, hasarlı bölgelerdeki hücreleri yenilemektedir. Bu sayede ameliyata gerek kalmadan tedavi imkânı sunmaktadır. Ayrıca, kırıkların iyileşmesini hızlandırmaktadır.Bunun yanı sıra kıkırdak dejenerasyonunu önlemek için de kullanılmaktadır. Bu sayede kök hücre tedavisi, ortopedi ve travmatoloji alanında cerrahi müdahalelere alternatif ve tamamlayıcı bir seçenek olarak öne çıkmaktadır.

Kök Hücre Tedavisinde Kullanılan Yöntemler ve Uygulama Alanları
Kök hücre tedavisinde farklı yöntemler kullanılarak çeşitli hastalıklar ve doku hasarları tedavi edilmektedir. En yaygın yöntemlerden biri, kemik iliği nakli, genellikle kan hastalıkları ve kanser tedavisinde uygulanmaktadır. Adipoz (yağ) dokusundan elde edilen kök hücreler ise ortopedi, dermatoloji ve estetik cerrahide sıkça tercih edilmektedir. Göbek kordonu kanından elde edilen kök hücreler, genetik hastalıklar ve bağışıklık sistemi bozukluklarının tedavisinde kullanılmaktadır. Ayrıca, PRP (platelet richplasma) ve kök hücre kombinasyonları, özellikle spor yaralanmaları ve eklem rahatsızlıklarında yenileyici özellikleri nedeniyle yaygın bir tedavi yöntemi haline gelmiştir. Her yöntemin uygulanma şekli, tedavi edilecek hastalığa ve hastanın genel sağlık durumuna göre belirlenmektedir.

Sıkça Sorulan Sorular ve Cevapları
1. Kök hücre tedavisi nedir ve nasıl uygulanır?
Kök hücre tedavisi, vücutta hasar görmüş dokuların ve organların onarılması için kök hücrelerin kullanıldığı bir tedavi yöntemidir. Gerektiğinde çeşitli hücre türlerine dönüşerek hastalıklı veya hasar görmüş hücrelerin yerine geçmektedir. Bu tedavi, hastalığın türüne ve hastanın ihtiyacına göre farklı kaynaklardan elde edilen kök hücrelerin vücuda enjekte edilmesi ya da doğrudan hasarlı bölgeye uygulanmasıyla gerçekleştirilmektedir.
2. Kök hücre tedavisi hangi hastalıklarda kullanılır?
Kök hücre tedavisi,
- Kanser (özellikle lösemi ve lenfoma)
- Kan hastalıkları (örneğin anemi)
- Nörolojik hastalıklar (Parkinson, Alzheimer)
- Omurilik yaralanmaları
- Kalp hastalıkları
- Diyabet
- Ortopedik rahatsızlıklar (kireçlenme, eklem problemleri) ve bazı genetik hastalıkların tedavisinde kullanılmaktadır. Ayrıca kozmetik ve dermatolojik uygulamalarda cilt yenileme ve doku onarımı için de tercih edilmektedir.
3. Kök hücreler vücutta nasıl işlev görür?
Kök hücreler, kendilerini yenileme ve spesifik hücre türlerine dönüşme yeteneklerine sahip olmaktadır. Hasarlı bölgelere uygulandıklarında, kök hücreler ihtiyaç duyulan hücrelere dönüşmektedir. Bu bölgede onarıcı süreçleri başlatmaktadırlar. Örneğin, eklemdeki hasarlı kıkırdak hücreleri yerine yeni kıkırdak hücreleri üretebilmekte veya kanser tedavisinde sağlıklı kan hücrelerinin yeniden üretilmesine yardımcı olabilmektedir.
4. Kök hücre tedavisinin başarı oranı nedir?
Başarı oranı, tedavi edilen hastalığa, hastanın genel sağlık durumuna ve kullanılan kök hücre türüne bağlı olarak değişmektedir. Kemik iliği nakli gibi bazı tedavilerde başarı oranı oldukça yüksek olabilir iken, nörolojik hastalıklardaki kök hücre tedavileri hala araştırma aşamasındadır. Kesin başarı oranları henüz tam olarak belirlenmemiştir.
5. Kök hücre tedavisi kimler için uygundur?
Kök hücre tedavisi, özellikle ciddi ve tedaviye dirençli hastalıkları olan hastalar için uygun olmaktadır. Ancak bu tedavi herkes için uygun olmayabilir. Hastanın genel sağlık durumu, yaşı, bağışıklık sistemi ve hastalığın türü göz önünde bulundurulması gerekmektedir. Tüm bunlar göz önüne alınarak doktorlar tarafından uygun bir tedavi planı belirlenmektedir. Kök hücre bağışçısı bulma gereksinimi de bazı durumlarda önemli bir faktör olmaktadır.
6. Kök hücre tedavisi nasıl elde edilir ve hangi kaynaklardan alınır?
Kök hücreler çeşitli kaynaklardan elde edilebilmektedir. En yaygın kaynaklar embriyonik kök hücreler, yetişkin kök hücreleri (kemik iliği, yağ dokusu, kan) ve göbek kordonu kanından alınan kök hücreler olmaktadır. Tedavi için kullanılacak kök hücreler, laboratuvarda çoğaltılabilir veya doğrudan hastanın kendisinden alınarak kullanılabilmektedir.
7. Kök hücre tedavisinin riskleri ve yan etkileri nelerdir?
Kök hücre tedavisi genellikle güvenli olarak kabul edilse de bazı riskler taşımaktadır. Her tedavide olduğu gibi yan etkiler de bulundurmaktadır. Bağışıklık sistemi reddi, enfeksiyon riski, tedavi edilen bölgedeki komplikasyonlar veya tümör gelişimi gibi yan etkiler nadir de olsa görülebilmektedir. Ayrıca kök hücrelerin yanlış bölgelere gitmesi ve beklenmeyen hücre tiplerine dönüşmesi de bir risk olmaktadır.
8. Kök hücre tedavisinin maliyeti ne kadar?
Kök hücre tedavisinin maliyeti, tedavi edilen hastalık, kullanılan kök hücre kaynağı ve uygulama yöntemi gibi faktörlere bağlı olarak değişiklik göstermektedir. Bu tedavi genellikle pahalı olabilir.Maliyetler tedavi merkezine, ülkeye ve kullanılan teknolojiye göre değişlik göstermektedir. Özellikle kemik iliği nakli gibi kompleks tedaviler daha yüksek maliyetlere sahip olmaktadır.
9. Kök hücre tedavisi sonrası iyileşme süreci ne kadar sürer?
İyileşme süresi, tedavi edilen hastalığa, hastanın durumuna ve tedavi yöntemine bağlı olmaktadır. Bazı hastalarda birkaç hafta içinde iyileşme belirtileri görülmeye başlar iken, bazı hastalarda tam iyileşme süreci aylar sürebilmektedir. Tedavi sonrası takip, iyileşmenin hızlanması ve olası yan etkilerin yönetilmesi için oldukça önemli rol oynamaktadır.
Op. Dr. Özgür Oktay Nar’dan Kök Hücre Tedavisi Hakkında Bilgilendirme
Op. Dr. Özgür Oktay Nar, kök hücre tedavisinin birçok hastalıkta umut vadeden bir yenileyici tedavi yöntemi olduğunu belirtmektedir. Kök hücreler, hasar görmüş dokuların onarılması ve yenilenmesi için kullanılan özel hücreler özelliğindedir. Özellikle ortopedi, travmatoloji, kan hastalıkları ve nörolojik rahatsızlıkların tedavisinde etkili sonuçlar sunan bu tedavi, cerrahi müdahalelere alternatif olarak hızla gelişmektedir. Dr. Nar, kök hücre tedavisinin, doğru hastaya ve uygun yöntemlerle uygulandığında yüksek başarı oranlarına sahip olduğunu vurgulamaktadır.
